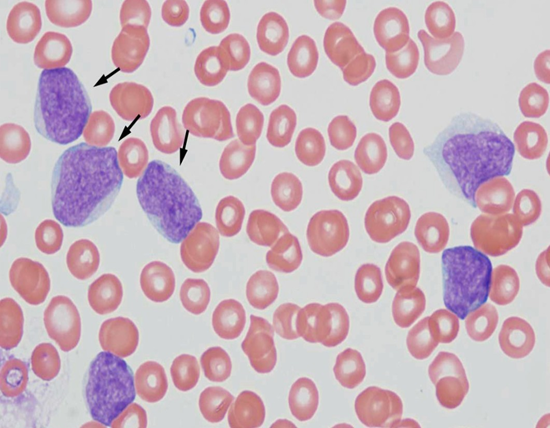

Mantle Cell Lymphoma with Tracheal Involvement
by Sana Eman*
Maidstone and Tunbridge Wells NHS Trust, UK
*Corresponding author: Sana Eman, Maidstone and Tunbridge Wells NHS Trust, UK
Received Date: 22 September 2025
Accepted Date: 26 September 2025
Published Date: 29 September 2025
Citation: Eman S. (2025). Mantle Cell Lymphoma with Tracheal Involvement. 10: 2421. https://doi.org/10.29011/2574-7754.102421
Abstract
Mantle cell lymphoma (MCL) is a type of mature B-cell non-Hodgkin lymphoma, characterized by a variable clinical course. It is one of the rarest forms of lymphoma, accounting for only 6% of non-Hodgkin lymphomas (NHL).
Tracheolaryngeal involvement in MCL is exceedingly rare and can present with acute airway obstruction, a potentially life-threatening condition. We report a case of a patient who initially presented with dyspnoea, a common clinical symptom. The patient was initially treated for an exacerbation of chronic obstructive pulmonary disease (COPD). However, the patient later developed stridor, and a CT scan revealed a mass in the proximal trachea, just below the level of the epiglottis. Due to severe airway obstruction, the patient underwent debulking surgery and tracheostomy.
Histopathological and immunohistochemical analyses subsequently confirmed the diagnosis of Blastoid-type mantle cell lymphoma. Given the aggressive nature of the lymphoma, the patient’s poor performance status, and the delayed diagnosis due to the rarity of the disease, palliative care was ultimately chosen. This case underscores the importance of considering urgent CT imaging of the neck and thorax in patients with a history of mantle cell lymphoma who present with dyspnoea, in order to rule out an airway mass.
Introduction
Mantle cell lymphoma (MCL) is a type of non-Hodgkin lymphoma, accounting for approximately 6% of cases. It is named after the mantle zone of the lymph nodes, where it typically develops [1].
MCL can involve lymph nodes as well as extranodal sites such as the gastrointestinal tract, blood, and bone marrow. It is usually composed of small to intermediate-sized lymphoid cells that express BCL2, CD5, and nuclear cyclin D1, while lacking CD23 expression. Nearly all cases exhibit the t(11;14) chromosomal translocation, which fuses the CCND1 gene (encoding cyclin D1) with the immunoglobulin heavy chain gene, resulting in cyclin D1 overexpression.
Most patients with MCL present with advanced-stage disease (stages III-IV).. Although MCL often progresses as an extranodal disease, involvement of the lung airway remains rare [1-6].
Here we report a case of MCL with airway involvement. We have confirmed this by cellular pathology report of biopsy.
Case Report
Our 85 year-old male patient presented with swelling of the left parotid and right mandibular glands for the past four weeks, along with a 2-day history of shortness of breath (SOB) and productive cough. His significant past medical history includes mantle cell lymphoma (MCL), for which he has been receiving treatment, including Rituximab with Bendamustine (Cycle 6, Day 1 on 02/04/24), Metoclopramide, co-trimoxazole, and acyclovir. On initial examination, he was tachypnoeic but able to speak in full sentences. His blood results showed a normal CRP but neutropenia, prompting the initiation of GCSF therapy. He was treated for a chest infection and an exacerbation of COPD based on his COPD history.
Progressively, he developed inspiratory stridor. A computed tomography (CT) scan of the neck, thorax, and abdomen revealed a 20mm mass in the proximal trachea, just below the epiglottis, with narrowing of the airway at the level of the vocal cords, likely secondary to oedema. In addition, there were enlarged bilateral
parotid and submandibular glands as described. The airway appeared patent radiologically. There was also an area of tree-in-bud nodularity in the right lung, likely infectious or inflammatory, which should be followed up on subsequent imaging.
After discussing with the haematology team, they advised that it was unlikely to be related to mantle cell lymphoma, given its rarity. They recommended transfer to the ENT team for airway management due to the obstruction and to perform a biopsy to identify the type of cancer. The patient was transferred to the ENT ward, where they performed debulking surgery and a tracheostomy, and sent biopsy samples to the lab. The cellular pathology report confirmed the diagnosis of Blastoid mantle cell lymphoma with lymphoblastic morphology, later confirmed by immunohistochemistry. The haematology MDT decided to pursue palliative care, considering the patient’s diagnosis of stage 4 Blastoid mantle cell lymphoma, an aggressive cancer (Figures 1, 2).

Figure 1: CT scan showed 20mm mass in the proximal trachea just below the level of the epiglottis. There was also narrowing of the airway at the level of the vocal cords which looks to be secondary to oedema.
Figure 2: Histopathology slide: Arrows in picture are pointed towards blastoid cell in mantle cell lymphoma.
Discussion
Mantle cell lymphoma (MCL) is a type of non-Hodgkin lymphoma that originates from B cells. It is named “mantle cell” lymphoma because the abnormal B cells typically develop in the mantle zone of the lymph nodes. There are two main types of mantle cell lymphoma:
Classical mantle cell lymphoma: This is the most common form and primarily affects the lymph nodes. It often spreads to other parts of the body, including the bone marrow, spleen, bowel, and liver. It is usually fast-growing, although in some cases, it may progress more slowly.
Leukemic non-nodal mantle cell lymphoma: This is a rarer form. Patients with this type commonly experience a swollen spleen and have lymphoma cells present in the bloodstream and bone marrow. It tends to grow more slowly compared to classical mantle cell lymphoma.
MCL is characterized by reciprocal chromosomal translocation t(11;14)(q13:q32), resulting in the juxta positioning of cyclin D1 locus to immunoglobulin heavy chain gene locus. This leads to constitutive expression of cyclin D1 (CCND1), which plays a significant role in tumour cell proliferation.
Histopathology:
Types: Diffuse > nodular > mantle zone growth patterns.
Nodal (> 50% nodular), diffuse growth pattern (< 50% nodular)
Variants
Aggressive variants
Blastoid: lymphoblast-like in appearance, monomorphism
Other variants Small cell.
Marginal zone-like.
Lymphoplasmacytic differentiation [7-9].
Radiographic features of pulmonary lymphoma on chest CT imaging are varied but classically present in one of three patterns. The most common appearance is that of scattered ill‐defined nodules with lower lobe predominance. The second most common pattern is a bronchovascular/lymphangitic process with coarse linear and reticulonodular shadows extending outwards from the hilum in a perivascular and peribronchial distribution. The third pattern is described as pneumonic/alveolar and is effectively indistinguishable from bacterial pneumonia . airway obstruction caused by the massive endobronchial growth of lymphoma cells is a very rare presentation of pulmonary lymphoma. It is well recognized that airway obstruction can be due to primary tracheal lymphoma or tracheobronchial compression by enlarged nodal lymphoma
Tracheobronchial involvement with mantle cell lymphoma is very rare (Figure 3). To the best of our knowledge, only four cases of MCL with tracheobronchial involvement have been previously reported [9].

Treatment: Mantle cell lymphoma (MCL) is among the most challenging B-cell lymphomas to treat. While conventional chemotherapy can induce high remission rates in newly diagnosed patients, relapse typically occurs within a few years, resulting in a median survival of only five to seven years. In addition to standard chemotherapy, three classes of novel agents proteasome inhibitors, mTOR inhibitors, and lenalidomide are available for the treatment of relapsed MCL. However, our understanding of their mechanisms of action and factors influencing their effectiveness remains limited. Therefore, patients with MCL should be encouraged to participate in clinical trials that incorporate robust translational research components [10].
In conclusion, tracheobronchial involvement in mantle cell lymphoma (MCL) is rare. A definitive diagnosis can be made through an endobronchial or endotracheal biopsy. Chest CT findings of the tracheobronchial wall should be carefully evaluated in patients with obstructive ventilatory dysfunction, as identified through Ct chest. If necessary, these findings should prompt efforts to obtain a tissue diagnosis.
References
- Depew ZS, and Vassallo R. (2012). Pulmonary mantle cell lymphoma: a rare manifestation of an uncommon condition. Rare Tumors 4: e11.
- Baheti AD, Tirumani SH, Sewatkar R. (2015). MDCT of extranodal mantle cell lymphoma: a single institute experience. Abdom. Imaging. 40: 1693-1699.
- Perez-Galan P, Dreyling M, Wiestner A. (2011). Mantle cell lymphoma: biology, pathogenesis, and the molecular basis of treatment in the genomic era. Blood. 117: 26-38.
- Perez-Galan P, Dreyling M, Wiestner A. (2011). Mantle cell lymphoma: biology, pathogenesis, and the molecular basis of treatment in the genomic era. Blood. 117: 26-38.
- Mantle cell lymphoma. Accessed in Online.
- Lynch DT, Koya S, Dogga S, Kumar A. (2023). Mantle Cell Lymphoma. StatPearls Publishing.
- Khanlari M, Young OC. (2020). Lymphoma & related disorders. Accessed from PathologyOutlines.com
- VI Podzolkov, TS Vargina, AE Pokrovskaya, TA Safronova, AA Abramova. (2018). Mantle Cell Lymphoma Case Report. Case Rep Oncol. 11: 814-821.
- Tong L, Gan G, Xu C, Yuan L, Li Z. (2018). Tracheobronchial involvement of mantle cell lymphoma. Respirol Case Rep. 6: e00346.
- Tong L, Gan G, Xu C, Yuan L, Li Z. (2018). Tracheobronchial involvement of mantle cell lymphoma. Respirol Case Rep. 6: e00346.
© by the Authors & Gavin Publishers. This is an Open Access Journal Article Published Under Attribution-Share Alike CC BY-SA: Creative Commons Attribution-Share Alike 4.0 International License. Read More About Open Access Policy.